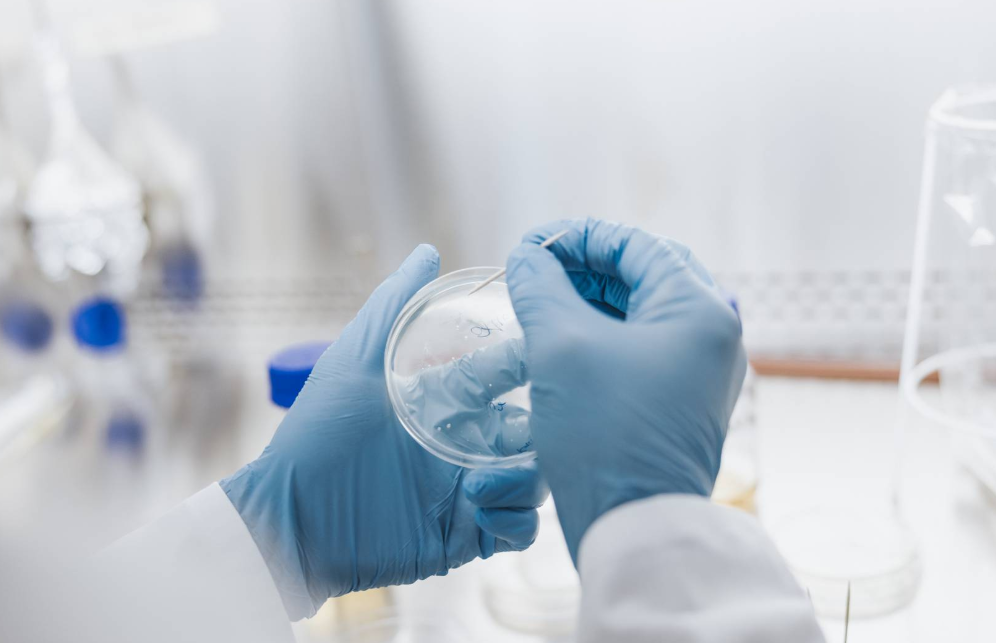

دراسة تكشف سر الوصول إلى عمر 100 عام
أزاح باحثون الستار عن اكتشاف علمي مثير يعزز فهمنا لكيفية العيش لفترة أطول وأكثر صحة، من خلال دراسة خلايا المعمرين الجذعية، وبينما يسعى العلماء لفهم العوامل البيولوجية المرتبطة بطول العمر، تشير نتائج الأبحاث الأخيرة إلى أن سر الوصول إلى عمر 100 عام قد يكمن في كيفية عمل خلايانا الجذعية وقدرتها على التجدد مع مرور الزمن.
ففي مدينة بوسطن، استطاع علماء أمريكيون إعادة برمجة خلايا جذعية مأخوذة من دم المعمرين. ويعتزم هؤلاء الباحثون مشاركة هذه الخلايا مع زملائهم في المجال لتحسين فهم العوامل التي تسهم في حياة طويلة وصحية. وتجدر الإشارة إلى أن هذه الدراسات المبكرة تقدم رؤى قيمة حول شيخوخة الدماغ.
ويقول جورج مورفي، عالم الأحياء في كلية الطب بجامعة بوسطن، وطبيب طب الشيخوخة توم بيرلز، اللذان قادا الدراسة المنشورة في مجلة "نيتشر" في نوفمبر 2024، إن المعمرين يشكلون فرصة ذهبية لدراسة عوامل طول العمر. فقد أظهرت الأبحاث أن أولئك الذين يعيشون حتى سن 100 عام لديهم قدرة مذهلة على التعافي من الأمراض. على سبيل المثال، تعافى أحد المعمرين من الإنفلونزا الإسبانية عام 1918، كما تعافى مرتين من مرض كوفيد-19.
تستند إحدى النظريات التي تفسر طول عمر المعمرين إلى امتلاكهم تركيبة جينية خاصة تحميهم من الأمراض. ومع ذلك، يصعب اختبار هذه النظرية نظرًا لندرة المعمرين، مما يجعل عينات دمهم غاية في الأهمية للبحث العلمي. لذا، قام مورفي وفريقه بإنشاء بنك خلايا يضم عينات من دم المعمرين لمشاركتها مع الباحثين الآخرين.
في هذه الدراسة، خضع المشاركون لاختبارات تقييمية لقدراتهم البدنية والعقلية، وتم جمع عينات دمهم للتحليل. وقد أظهرت النتائج أن العديد من المعمرين كانوا يتمتعون بصحة عقلية جيدة وكانوا قادرين على العناية بأنفسهم. قام فريق البحث بعزل خلايا الدم لـ30 معمرًا وتحويلها إلى خلايا جذعية متعددة القدرات، مما يتيح للباحثين دراسة العوامل الوراثية المؤثرة على الشيخوخة دون تغيير الشيفرة الجينية.
كما بحث الباحثون عن أشخاص في سن 100 عام أو أكثر عبر قوائم الناخبين ومنشآت الرعاية طويلة الأمد. وقد عبر الكثير من المشاركين عن رغبتهم في المشاركة في الدراسة، مُدركين أهمية ما يقومون به.
تشير النتائج الأولية إلى أن الخلايا العصبية المأخوذة من المعمرين أظهرت كفاءة أكبر في التعامل مع الإجهاد مقارنة بالخلايا المأخوذة من الأشخاص الأصغر سنًا. كما أظهرت الدراسات أن المعمرين يمتلكون مستويات أعلى من الجينات المرتبطة بالحماية ضد أمراض مثل ألزهايمر وباركنسون.
علاوة على ذلك، كانت هناك أبحاث أخرى قد استخدمت خلايا المعمرين لإنشاء نماذج دماغية ثلاثية الأبعاد لمرض ألزهايمر، حيث أظهرت النتائج أن الخلايا المستخلصة من المعمرين تحتوي على مستويات أعلى من الجينات التي تحمي من هذا المرض.
فيما يخص التجارب المستقبلية، يخطط الباحثون لتوسيع دراستهم لتشمل خلايا أخرى مرتبطة بالشيخوخة مثل خلايا الكبد والعضلات والأمعاء، مما قد يفتح آفاقًا جديدة لفهم الشيخوخة وكيفية محاربتها.
أما في مجال آخر من أبحاث الخلايا الجذعية، قام فريق من العلماء بقيادة دينغ هونغكوي، عالِم الأحياء في جامعة بكين، بتطوير تقنية لإعادة برمجة خلايا مرضى السكري من النوع الأول إلى خلايا جذعية متعددة القدرات. واستخدم الفريق هذه الخلايا لإنتاج جزر بنكرياس اصطناعية يمكنها إنتاج الإنسولين، وقد أظهرت التجارب الأولية نتائج مشجعة، حيث بدأت إحدى المشاركات في الدراسة في إنتاج الإنسولين بشكل مستقل بعد عملية زرع جزر البنكرياس في عضلات بطنها.
ويأمل الباحثون في توسيع هذه الدراسات لتشمل مزيد من المرضى والعمل على تحسين التقنيات المستخدمة لضمان نجاح أكبر في المستقبل.





















